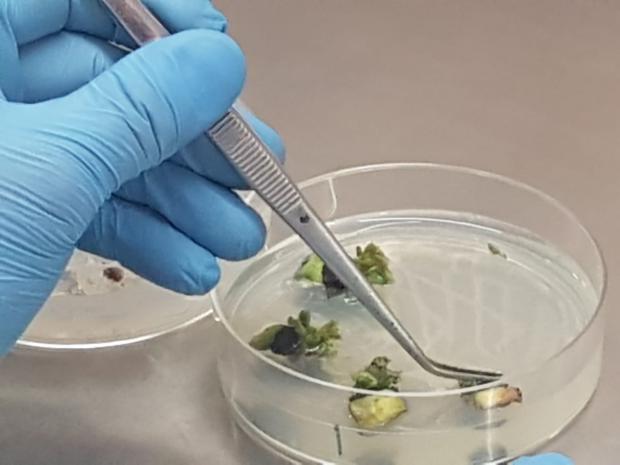
service-img3

Portaria estabelece os valores atualizados das taxas de sementes e mudas
PORTARIA MAPA NO 647, DE 30 DE JANEIRO DE 2024
Fixa os valores atualizados das taxas de Sementes e Mudas, declara nula a Portaria MAPA n° 644, de O8 de janeiro de 2024, e revoga a Instrução Normativa MAPA no 34, de 9 de setembro de 2014.
O MINISTRO DE ESTADO DA AGRICULTURA E PECUÁRIA, no uso das atribuições que lhe confere o art. 87, parágrafo único, inciso ll, da Constituição, e tendo em vista o disposto na Lei n° 10.711, de 5 de agosto de 2003, no Decreto n° 10.586, de 18 de dezembro de 2020, e o que consta do Processo n° 21OOO.049888/2023-53, resolve:
Art. 1º Fixar os valores atualizados das taxas de Sementes e Mudas, na forma do Anexo.
Art. 2º O pagamento pelos serviços públicos prestados ocorrerá por meio de Guia de Recolhimento da União, na qual deverá constar a Unidade Gestora - UG responsável pelo controle do serviço prestado, ou por processo automatizado em sistema oficial.
§ 1º No caso de inscrição ou alteração no Registro Nacional de Cultivares (RNC), a UG será a Secretaria de Defesa Agropecuária do Ministério da Agricultura e Pecuária.

 § 2º No caso de inscrição ou credenciamento no Registro Nacional de Sementes e Mudas (RENASEM), a UG será a Superintendência do Ministério da Agricultura e Pecuária na unidade federativa onde o interessado estiver estabelecido.
§ 2º No caso de inscrição ou credenciamento no Registro Nacional de Sementes e Mudas (RENASEM), a UG será a Superintendência do Ministério da Agricultura e Pecuária na unidade federativa onde o interessado estiver estabelecido.
§ 3º No caso de inscrição de campo de sementes, de planta básica, de planta matriz, de planta fornecedora de material de propagação sem origem genética comprovada, de viveiro e de unidade de propagação in vitro, a UG será a Superintendência do Ministério da Agricultura e Pecuária na unidade federativa onde ocorrerá a produção.
Art. 3º A fórmula base para o cálculo da atualização monetária é V g' V n I, onde: I - V r - Fepresentao valor real ou atualizado;
ll - V n - é o valor nominal vigente; e
III - I - é o índice de correção acumulado de 12 meses.
Parágrafo único. No caso das taxas aplicadas para sementes e mudas será aplicado o Índice Nacional de Preços ao Consumidor (INPC).
Art. 4º A atualização do valor das taxas conforme o art. 3º ocorrerá no primeiro dia útil de cada ano.
Art. 5º A vigência do valor atualizado das taxas passa a vigorar em 1º de fevereiro de cada ano.
§ 1º Para fins da aplicação do disposto no caput, será considerada a data de início da contagem
do prazo estabelecido para a inscrição da produção de sementes, de material de propagação ou de mudas no Ministério da Agricultura e Pecuária.
§ 2° A tabela com os índices atualizados será disponibilizada no sítio eletrônico do Ministério da Agricultura e Pecuária.
Art. 6° Fica declarada nula a Portaria MAPA n° 644, de 08 de janeiro de 2024, de modo que permanece vigente a Portaria lnterministerialn° 531, de 13 de outubro de 1994.
Art.7° Fica revogada a Instrução Normativa MAPA n° 34, de 9 de setembro de 2014. Art. 8º Esta Portaria entra em vigor na data de sua publicação.
VALORES DAS TAXAS DE SEMENTES E MUDAS
Tabela. Valores das taxas de sementes e mudas
|
||||||||||||||||||||||||||||||||||||||||||||||||||||||||||||||||||||||||||||||||||||||||||||||||||||||||||||||||||||||||
